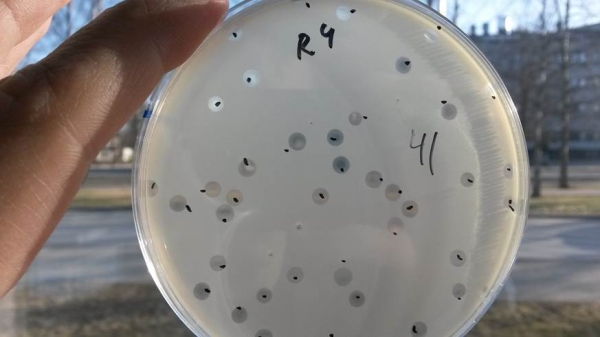
Ali Baba and fourty thieves a.k.a 41 T7 bacteriophages amplifying on the E. coli agar plate.

Peptide targeted polymersomes bind to M2 human macrophages
Polymersomes targeted with an M2 macrophage binding peptide in a mouse model of triple negative breast cancer
Long persistence of an M2 TAM internalizing peptide in breast tumors
Linear TT1 peptide-coupled FAM-labeled iron oxide nanoparticles home to blood vessels of subcutaneous U87 tumor xenograft
Dark-field image of silver nanoparticles with RPARPAR-MMAE-AgNP internalized by PPC-1 prostate cancer cells
Dark-field image of silver nanoparticles with cytotoxic drug monomethyl auristatin E and RPARPAR peptide (RPARPAR-MMAE-AgNP) internalized by PPC-1 prostate cancer cells after 1 h incubation. Extracellular fraction of AgNPs was removed by etching. Scale bar: 20 μm; dotted lines outline cells. Author: Allan Tobi MSc.
PET-CT image of breast tumor bearing mouse i.v. injected with iRGD targeted nanoparticles
Targeting-polymeric nanoparticles are internalized in MCF-7 and U87 spheroids
Fluorescein-labeled polymeric nanoparticles functionalized with a targeting peptide (in green) are internalized into MCF-7 (from breast tumor) and U87 (from glioblastoma) spheroids that express the NRP-1 receptor (in red). The nanoparticles are observed inside the U87 cells (white arrow). Scale bar are 200 µm and 20 µm (in the big magnification).
Authors: Lorena Simón-Gracia, Ines Diaz Bessone, Kadri Toome
Intravenously injected "UNO" peptide enters protumoral macrophages
Nanoparticles homing to breast tumor
Left: electron microscopy images of polymeric nanoparticles targeted with tumor penetrating peptide loaded with cancer drug. Right: Confocal microscopy pictures of tumor, kidney, and liver tissue sections of mouse bearing breast tumor i.v. injected with nanoparticles loaded with cancer drug.
Authors: Ines Diaz Bessone PhD, Pablo David Scodeller PhD, Lorena Simon Gracia PhD
Two-photon image of blood vessels with Evans Blue after tail vein injection
The "UNO" peptide recognizes circulating tumor associated macrophages
TT1-FAM-IONW
A peptide identified in the lab using in vivo phage display homes to tumor macrophages in a mouse model of a highly metastatic human gastric cancer, MKN45-P
In vivo imaging of a mouse bearing luciferase-expressing MKN-45 gastric carcinoma.
Selective internalization of RPARPAR silver nanoparticles (Ag-RPARPAR) in NRP-1 expressing cells. In mixed culture, Ag-RPARPAR are taken by NRP-1 (green)-expressing PPC1 prostate carcinoma cells but not by M21 melanoma cells not expressing NRP-1.
Transmission electron microscope image of hybrid silver/polymeric nanoparticles (NPs)
Penetration of uCendR-RGD peptide to 4T1 breast tumors in vivo
uCendR peptide was designed by positioning the cryptic CendR motif in the context of recognition and cleavage site of a tumor-associated protease, urokinase-type plasminogen activator (uPA). FAM-labeled uCendR peptide containing additional RGD vascular recruitment module was injected into 4T1breast tumor mice, after 3hr circulation the mice were perfused with PBS and tumors sectioned for microscopy. Confocal microscopy confirmed the accumulation of synthetic uCendR-RGD peptide (green) in tumor tissue, and revealed extravasation and spreading within the tumor. CD31- positive tumor blood vessels (bv) – red.
Author: Tambet Teesalu, PhD